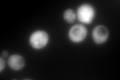
YHR183W

View description
6-phosphogluconate dehydrogenase (decarboxylating), catalyzes an NADPH regenerating reaction in the pentose phosphate pathway; required for growth on D-glucono-delta-lactone and adaptation to oxidative stress
Localization:
Intensity:
Fold change:
Significance:
-
C’ GFP library in SD

cytosol2080.94 -
N' NOP1pr-GFP in SD

cytosol306.152 -
N' TEF2pr-mCherry in SD

cytosol331.634 -
N' NATIVEpr-GFP in SD

cytosol749.704 -
N' TEF2pr-VC and Cyto-VN in SD

#N/A0 -
C’ GFP library in SD+DTT

cytosol2080.951No -
C’ GFP library in SD+H2O2
cytosol2080.951No -
C’ GFP library in Starvation Media

nucleusN/AN/AYes -
C’ GFP library on the background of Pup2-DaMP

cytosol -
C’ GFP library on the background of CCT mutant

cytosol1973.620.94842No
